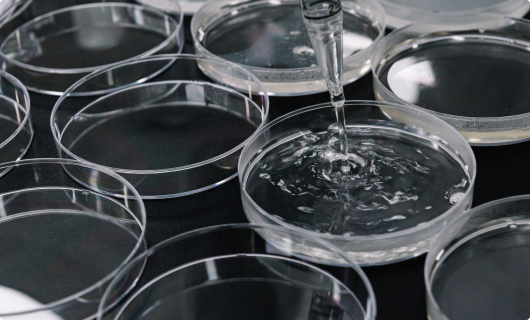

介绍
追求培养创意性实务能力的差异化人才,是西南圈生活环境工程部的最高学府
生活环境工程部为了发挥首都圈西南部知识基础产业发展的中枢作用,培养的目标人才有:第4产业时代的,具有创意性、实务能力的人才,在建筑、室内、视觉领域设计系和以食品安全和品质管理及生命化工和基因领域差异化专业人才。

-
生命化学工程科
未来的生命工程学由我们负责
生命化学工程学是融合尖端技术领域生命工程学和传统技术领域的化学工学进行教育的学科,目标是培养兼备专业知识和实务能力,具备正确职业道德的创意性专业技术人员。将专业教育内容细分为生物医药制造及品质管理领域、炼油•石油制品制造及品质管理领域,指导具备符合各职务领域特点的专业知识、技术和素养。毕业后将在生命工程学、生物医药、制药、化妆品、炼油及石油化学等多个领域具备尖端技术的企业就职。


-
生物融合工程科
梦想成为引领未来尖端生物领域的专家
生物融合工程科是以第4次产业革命的核心技术生物为中心,融合医药、化学、食品、化妆品、环境等多种学科进行教育的学科,目标是培养兼具尖端知识和实务能力的生物产业领域专业技术人才。

-
建筑科
培养建筑工程&建筑设计领域的特性化专业技术人才
建筑科针对第4产业的扩散、数字建筑的产业化、碳中立政策等产业环境、以培养能够灵活应对相关政策变化和要求的实务型专业技术人才为目标,运营符合建筑工学及建筑设计专业、可应用于实务的特色现场中心教育课程,为提高就业率,与优秀产业企业保持着紧密的产业学术合作体制。


-
室内建筑设计科
虚拟世界(Meta-verse)时代的新型空间创造的主战场,在这里实现你的梦想吧
室内建筑设计科在新冠肺炎疫情以后,成为了配合着新标准时代变化无穷的时空拼图碎片,"带来新经验的讲述者"的工作室。这里有充满历史和文化理解的共鸣和沟通能力、用合理的知识和智能技术锻炼的问题解决能力,是个打造创造性时空管弦乐团的指挥家梦想的地方。让我们通过如同实际产业现场的尖端镜面型实习环境和以多样的实务能力倾泻出无私智慧的专业教授团队,通过大家主导的主动项目式学习系统,尽情展开创新型室内建筑设计师的梦想之翼吧。


-
视觉设计科
多样的视觉设计领域中活跃的实务型设计人才
视觉信息设计科把教育的重点放在培养能够有机应对当今快速变化的视觉环境的视觉交流员上。我们运营着能接触广告、编辑、多媒体、影像等多种视觉设计领域的教育课程,以创造性思维教育为基础,具备卓越的造型能力,并同时进行可以有机应对适用于多种媒体的设计表现的技能教育和理论教育。


-
AR · VR内容设计学科
培养数字设计内容、沉浸式内容等设计产业所需的融合型人才
第四次工业革命的核心产业——AR、VR、MR、XR及元宇宙等沉浸式内容产业,作为第四次工业革命的关键词之一,正在受到全球关注,并且其规模逐渐扩大,已成为国家未来产业的重要组成部分。为了适应这一时代趋势,AR·VR内容设计专业的教育目标是培养能够将曾主要应用于电影、游戏、数字音源等娱乐产业的数字设计内容,随着ICT的进步,扩展并应用于更广泛的设计产业领域的专业人才。


| 学科 | 行政担当 | 办公室位置 | Phone | FAX | |
|---|---|---|---|---|---|
| 生命化学工程科 | M****** Park | Building 4, Room 306 | 02-2610-1820 | 02-2610-1858 | mwpark@dongyang.ac.kr |
| 生命化学工程科 | M***** Lee | Building 4, Room 306 | 02-2610-1812 | 02-2610-1858 | minseo9@dongyang.ac.kr |
| 生命化学工程科 | D***** Lee | Building 5, Room 202 | 02-2610-1851 | 02-2610-1988 | ldy1203@dongyang.ac.kr |
| 建筑科 | J****** Won | Building 7, Room 301 | 02-2610-1886 | 02-2610-1857 | jgone@dongyang.ac.kr |
| 建筑科 | J****** Lee | Building 7, Room 301 | 02-2610-1802 | 02-2610-1857 | twojy@dongyang.ac.kr |
| 建筑科 | J**** Hwang | Building 7, Room 301 | 02-2610-1801 | 02-2610-1857 | wlsgk961205@dongyang.ac.kr |
| 室内建筑设计科 | H***** Bang | Building 7, Room 301 | 02-2610-1969 | 02-2610-1960 | hoyeon@dongyang.ac.kr |
| 视觉设计科 | H***** Yang | Building 7, Room 301 | 02-2610-1962 | 02-2610-1960 | didgals@dongyang.ac.kr |
